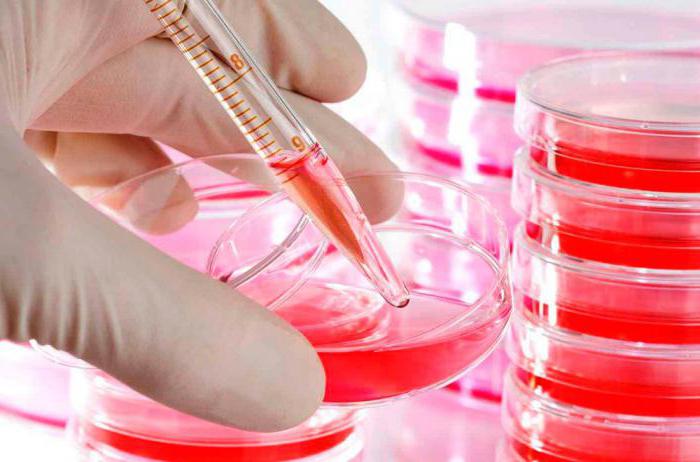

MPV (средний объем тромбоцитов) — ключевой показатель в анализе крови, который оценивает состояние тромбоцитарной системы и помогает выявить заболевания. В статье рассмотрим, что такое MPV, как его расшифровать, нормы для мужчин, женщин и детей, а также действия при его повышении или понижении. Понимание этого показателя способствует своевременной диагностике и профилактике заболеваний, связанных с нарушением гемостаза, что делает информацию полезной для заботящихся о своем здоровье.
MPV в крови: тромбоцитарный индекс и норма
Буквосочетание MPV расшифровывается как mean platelet volume, что в переводе означает «средний объем тромбоцитов» или тромбоцитарный индекс. Тромбоциты – это клетки крови, играющие ключевую роль в процессе гемостаза. Они обеспечивают свёртываемость, что позволяет организму избежать значительной потери крови даже при незначительных повреждениях сосудов. Анализ показателя MPV помогает оценить способность крови к свёртыванию. Любые изменения в количестве тромбоцитов, как в большую, так и в меньшую сторону, могут служить сигналом для беспокойства и требуют более детальной диагностики.
Обратите внимание!
При анализе тромбоцитарного индекса рассматриваются зрелость клеток, их размер и количество на один кубический миллиметр крови.
Оценка MPV:
- осуществляется через общий анализ крови;
- помогает выявить заболевания и их причины, начиная от болезней сосудистой системы и заканчивая патологиями половой системы.
Чтобы определить нормальный уровень MPV, требуется специальный анализ, так как в рамках общего исследования крови этот показатель может не быть заметным. Нормальные значения индекса находятся в диапазоне от 7 до 11 фл.
MPV, или средний объем тромбоцитов, является важным показателем в анализе крови, который может многое рассказать о состоянии здоровья пациента. Врачи отмечают, что этот параметр помогает оценить активность тромбоцитов и их способность к образованию тромбоцитов. Повышенный уровень MPV может указывать на наличие воспалительных процессов или заболеваний, таких как тромбоцитопения, тогда как пониженный уровень может свидетельствовать о нарушениях в кроветворении.
Специалисты подчеркивают, что интерпретация MPV должна проводиться в комплексе с другими показателями общего анализа крови. Например, сочетание повышенного MPV с низким количеством тромбоцитов может указывать на риск тромбообразования. Важно, чтобы пациенты не игнорировали результаты анализов и обсуждали их с врачом, так как только квалифицированный специалист может правильно расшифровать данные и назначить необходимое лечение.

Изучение тромбоцитарного индекса
Образец крови для анализа MPV исследуется с использованием специального флуоресцентного цитометрического метода. Для получения достоверных результатов требуется объем не менее 5 мл. Чтобы максимально точно оценить уровень MPV, исследование следует проводить в течение двух часов после забора крови.
Результаты анализа представляются в виде гистограммы. К сожалению, как врачи, так и пациенты иногда недооценивают значение MPV. Однако этот показатель является важным элементом анализа.
MPV не только отражает количественные характеристики тромбоцитов, но и позволяет оценить их качество: размер, подвижность, склонность к агрегации и другие важные функции.
Методы лабораторной диагностики:
-
Определение капиллярной резистентности. Этот общий анализ включает обязательное выполнение манжеточной и баночной проб, подсчет уровня MPV и определение времени кровотечения по методу Дьюка. Если после первого этапа резистентность капилляров считается пониженной, это означает, что количество маленьких красных пятен на коже значительно превышает норму, установленную для здоровых людей. Затем под микроскопом подсчитывается общее количество тромбоцитов, нормой считается 200-400х10/л. При значительном снижении этого показателя риск кровотечения возрастает. По методу Дьюка время кровотечения должно составлять до 300 секунд. Оценка резистентности производится на основе трех исследований. Низкий уровень резистентности может привести к развитию других заболеваний;
-
Второй метод позволяет определить клиническое значение MPV. Исследуется ретенция тромбоцитарных свойств крови при контакте со стеклом. Нормальные значения ретенции составляют от 20% до 50%. Далее изучается агрегация тромбоцитов с графической регистрацией процесса. Плотность тромбоцитов оценивается после добавления АДФ, при этом фиксируется минимальное значение, на которое реагируют клетки. Слишком низкий порог указывает на повышенную склонность тромбоцитов к тромбообразованию. Резкие колебания в тромбообразовании также могут быть связаны с недостатком необходимых веществ. Последний показатель — уровень рецепторов, способных противостоять антибиотикам. Чем выше этот показатель, тем лучше.
Нормы для мужчин, женщин и детей, а также для беременных женщин представлены в таблице:
| Категория граждан | Норма тромбоцитов |
| Мужчины | 180-320х10 |
| Женщины | 180-320х10 |
| Дети | 160-360х10 |
| Беременные женщины | 140-320х10 |
Важно учитывать, от чего зависит уровень тромбоцитов у различных людей:
- время суток;
- время года;
- у женщин — фаза менструального цикла;
- наличие заболеваний и патологических процессов в организме.
Также значим качественный показатель, который оценивается отдельно.
PLT в анализе крови: что это такое, нормы и причины отклонений. PLT представляют собой мелкие фрагменты клеток, необходимые для нормального процесса свертывания крови.
| Показатель | Что означает | Нормальные значения |
|---|---|---|
| MPV (Mean Platelet Volume) | Средний объем тромбоцитов. Показывает размер тромбоцитов в крови. | 7.4 — 10.4 фемтолитров (фл) |
| Повышенный MPV | Указывает на наличие более крупных, молодых и активных тромбоцитов. Может наблюдаться при:
|
> 10.4 фл |
| Пониженный MPV | Указывает на наличие более мелких, старых или неактивных тромбоцитов. Может наблюдаться при:
|
< 7.4 фл |
Подготовка к исследованию
Расшифровка анализа MPV может указывать на повышенную агрегацию тромбоцитов, возможные активные кровопотери, тромбоз, а также на миелопролиферативные заболевания. Исследование осуществляется путем анализа.
Пациентам следует придерживаться следующих рекомендаций:
- За 8 часов до анализа разрешается только пить простую негазированную воду;
- За 5 часов до процедуры необходимо отказаться от курения (включая электронные сигареты);
- За день до анализа исключить из рациона жирную, слишком соленую и острую пищу;
- За месяц до исследования не принимать гормоносодержащие препараты;
- Не проводить анализ сразу после клинических процедур, таких как УЗИ, биопсия или компьютерная томография.
Чтобы облегчить неприятные ощущения после анализа, рекомендуется повысить уровень глюкозы в организме.
Важно!
Нормальные показатели анализа показывают соотношение зрелых, старых, новообразованных и дегенеративных клеток. В соответствии с нормой, доля дегенеративных клеток не должна превышать 0,3%, зрелых клеток – 90%, старых – 6%, а вновь образовавшихся – до 1%.
Расшифровка норм тромбоцитов у детей демонстрирует, что колебания в одном и том же возрасте могут быть значительными. Это связано с резкими скачками роста и изменениями гормонального фона у ребенка.
По результатам анализа MPV у женщин в период беременности нормы могут варьироваться в зависимости от гормонального фона. Во время беременности гормональный баланс несколько раз перестраивается, подготавливая организм к новому этапу. Резкий рост уровня наблюдается в момент формирования кровеносной системы плода, поскольку он заимствует клетки матери, что требует от нее большего количества собственных. В этот период анализ на тромбоциты проводится регулярно, так как любые изменения в уровне свёртываемости крови могут представлять угрозу для жизни как матери, так и ребенка.

Отклонения от нормы: высокий и низкий показатель
Снижение уровня MPV в анализе крови может быть вызвано рядом различных факторов. Это состояние указывает на уменьшение количества тромбоцитов, когда старые клетки преобладают над новыми. Временные колебания уровня тромбоцитов, например, у беременных женщин или подростков, считаются нормальными. Однако постоянное понижение уровня белых клеток крови может свидетельствовать о тромбоцитопении, что приводит к снижению свёртываемости крови.
Причины понижения уровня MPV:
- Нарушения в распределении тромбоцитов, часто возникающие на фоне других заболеваний, таких как бронхит, астма или туберкулёз.
- Полное прекращение производства новых клеток, что может происходить при злоупотреблении алкоголем или наркотиками.
- Увеличение скорости разрушения тромбоцитов, превышающей скорость их образования.
Пациенты могут заметить симптомы низкого уровня MPV еще до визита к врачу. Женщины могут столкнуться с сильными и продолжительными менструациями (более 8 дней), тогда как мужчины и дети чаще испытывают носовые кровотечения. Все группы риска также могут наблюдать кровоизлияния в сетчатке глаз и появление множества синяков по телу.
Если уровень MPV повышен, это означает, что количество тромбоцитов в крови значительно превышает норму. Увеличенное образование тромбоцитов может привести к повышенному риску образования тромбов, что затрудняет нормальное кровообращение. Это состояние называется тромбоцитозом.
Причины повышения уровня MPV:
- Избыточное количество молодых клеток, что может произойти после хирургических операций или переливания крови.
- Нарушения в процессе кроветворения и увеличение числа дегенеративных клеток.
- Обострение хронических заболеваний пищеварительной системы, опорно-двигательного аппарата или заболеваний крови.
Как восстановить уровень MPV
Для решения проблем, связанных с пониженным и повышенным уровнем MPV, применяются различные подходы.
Важно знать!
При повышенном уровне MPV назначаются антикоагулянты, которые помогают восстановить нормальную концентрацию крови. Также необходимо исключить и исследовать возможные причины данного нарушения.
Для диагностики проводятся анализы мочи, биохимические исследования, ультразвуковое обследование органов малого таза и других органов по указанию врача, а также анализ гормонального фона.
В случае пониженного уровня MPV акцент делается на профилактические меры, направленные на улучшение психологического состояния пациента:
- устранение стрессовых факторов;
- увеличение физической активности;
- нормализация режима труда и отдыха;
- обеспечение восьмичасового сна каждый день.
Среди медикаментов могут быть назначены антикоагулянты длительного действия, такие как Варфарин, Синкумар и Фенилин.
Анализ на уровень тромбоцитов не является самостоятельным исследованием. Рекомендуется проводить его не чаще одного раза в месяц, чтобы клетки успели восстановиться и результаты были более точными.
При появлении любых симптомов, связанных с повышением или понижением уровня тромбоцитов, стоит незамедлительно обратиться к врачу для дальнейшего контроля.
https://youtube.com/watch?v=xrHIfHMle-8
Причины изменений уровня MPV
Изменения уровня MPV (средний объем тромбоцитов) в анализе крови могут быть вызваны различными факторами, которые отражают состояние организма и его реакцию на различные заболевания или внешние воздействия. Понимание этих причин позволяет врачам более точно интерпретировать результаты анализов и назначать соответствующее лечение.
Одной из основных причин повышения уровня MPV является активная тромбоцитарная реакция на воспалительные процессы. При наличии воспаления в организме, например, при инфекциях или аутоиммунных заболеваниях, происходит стимуляция костного мозга, что приводит к образованию более крупных тромбоцитов. Эти клетки обладают большей функциональной активностью и способны быстрее реагировать на повреждения сосудов.
Снижение уровня MPV, в свою очередь, может быть связано с различными патологиями, такими как тромбоцитопения (уменьшение количества тромбоцитов в крови), которая может возникать при заболеваниях печени, некоторых формах рака или в результате воздействия лекарственных препаратов. В таких случаях меньший объем тромбоцитов может указывать на их недостаточное образование или повышенное разрушение в организме.
Кроме того, уровень MPV может изменяться под воздействием факторов образа жизни, таких как курение, алкоголь и физическая активность. Например, курение может приводить к увеличению MPV, так как никотин и другие вещества, содержащиеся в табаке, влияют на состояние сосудов и тромбоцитов. Алкоголь, в свою очередь, может снижать уровень MPV, особенно при злоупотреблении, что связано с токсическим воздействием на костный мозг.
Также стоит отметить, что уровень MPV может варьироваться в зависимости от возраста и пола пациента. У новорожденных и детей уровень MPV обычно выше, чем у взрослых, что связано с особенностями формирования кроветворной системы. У женщин уровень MPV может изменяться в зависимости от фазы менструального цикла, что также следует учитывать при интерпретации результатов анализов.
Таким образом, уровень MPV является важным показателем, который может отражать не только состояние тромбоцитов, но и общее состояние организма. Для точной диагностики и назначения лечения необходимо учитывать все возможные причины изменений этого показателя, а также сопутствующие симптомы и результаты других анализов.
Влияние MPV на здоровье и риск заболеваний
Средний объем тромбоцитов (MPV) является важным показателем, который может дать ценную информацию о состоянии здоровья человека и его предрасположенности к различным заболеваниям. Изменения в уровне MPV могут указывать на наличие воспалительных процессов, сердечно-сосудистых заболеваний, а также других патологий.
Нормальные значения MPV варьируются в пределах 7.5-11.5 фемтолитров (фл). Увеличение MPV может свидетельствовать о повышенной активности тромбоцитов, что связано с их более крупным размером. Это может быть признаком различных заболеваний, таких как тромбоцитопения, воспалительные процессы или даже некоторые виды рака. В то же время, низкий уровень MPV может указывать на недостаточную продукцию тромбоцитов в костном мозге или их повышенное разрушение, что также может быть связано с рядом заболеваний, включая аутоиммунные расстройства.
Исследования показывают, что высокий MPV ассоциируется с повышенным риском сердечно-сосудистых заболеваний. Это связано с тем, что более крупные тромбоциты имеют более высокую активность и могут способствовать образованию тромбов, что увеличивает вероятность инсульта или инфаркта миокарда. Кроме того, повышенный уровень MPV может быть связан с диабетом, гипертонией и другими метаболическими нарушениями.
С другой стороны, низкий MPV может быть связан с повышенным риском кровотечений, так как меньшие тромбоциты могут быть менее эффективными в процессе гемостаза. Это может привести к различным осложнениям, особенно у пациентов с заболеваниями печени или у тех, кто принимает антикоагулянты.
Важно отметить, что MPV не является изолированным показателем и должен рассматриваться в контексте других анализов и клинической картины пациента. Например, сочетание высокого MPV с другими показателями, такими как уровень холестерина или воспалительные маркеры, может дать более полное представление о состоянии здоровья пациента и его рисках.
Таким образом, мониторинг уровня MPV может быть полезным инструментом для оценки здоровья и выявления потенциальных рисков заболеваний. Регулярные анализы крови, включая определение MPV, могут помочь в ранней диагностике и профилактике различных заболеваний, что в конечном итоге способствует улучшению качества жизни и здоровья пациентов.
Методы лабораторного определения MPV
Средний объем тромбоцитов (MPV, от англ. Mean Platelet Volume) является важным показателем, который помогает в оценке состояния кровеносной системы и диагностики различных заболеваний. Существует несколько методов лабораторного определения MPV, каждый из которых имеет свои особенности и преимущества.
Первый и наиболее распространенный метод — это автоматический анализ крови с использованием гематологических анализаторов. Эти устройства позволяют быстро и точно измерять различные параметры крови, включая MPV. Анализаторы работают на основе принципа лазерной диффракции или электрической импедансной цитометрии. В первом случае, кровь проходит через лазерный луч, и изменение света, отраженного от клеток, позволяет определить их размер. Во втором случае, клетки проходят через узкое отверстие, и изменение электрического сопротивления позволяет измерить их объем.
Автоматические анализаторы обеспечивают высокую точность и воспроизводимость результатов, что делает их предпочтительными для клинических лабораторий. Однако важно отметить, что для получения достоверных результатов необходимо правильно подготовить образец крови, включая соблюдение условий хранения и транспортировки.
Второй метод — это ручной подсчет тромбоцитов под микроскопом. Этот метод менее распространен в современных лабораториях, но все еще используется в некоторых случаях, особенно в небольших клиниках или в условиях, где нет доступа к автоматическим анализаторам. Для этого метода требуется окрашивание образца крови, что позволяет визуально различать тромбоциты и оценивать их размер. Хотя этот метод может быть полезен, он менее точен и более трудоемок, чем автоматизированные методы.
Третий метод включает использование специальных тестов на основе флуоресцентной цитометрии. Этот метод позволяет не только измерять MPV, но и проводить более детальный анализ тромбоцитов, включая их активацию и агрегацию. Флуоресцентные метки, прикрепленные к антителам, связываются с тромбоцитами, что позволяет исследовать их характеристики на молекулярном уровне.
Важно отметить, что результаты анализа MPV могут варьироваться в зависимости от метода исследования, поэтому для точной интерпретации данных необходимо учитывать используемую методику. Кроме того, на уровень MPV могут влиять различные факторы, такие как возраст, пол, наличие заболеваний и даже время суток, когда был проведен анализ. Поэтому для получения полной картины состояния здоровья пациента рекомендуется рассматривать MPV в сочетании с другими гематологическими показателями.
В заключение, выбор метода определения MPV зависит от доступности оборудования, специфики клинической ситуации и требований к точности результатов. Автоматические анализаторы остаются наиболее предпочтительными благодаря своей высокой эффективности и надежности, однако ручные методы и флуоресцентная цитометрия также могут быть полезны в определенных условиях.